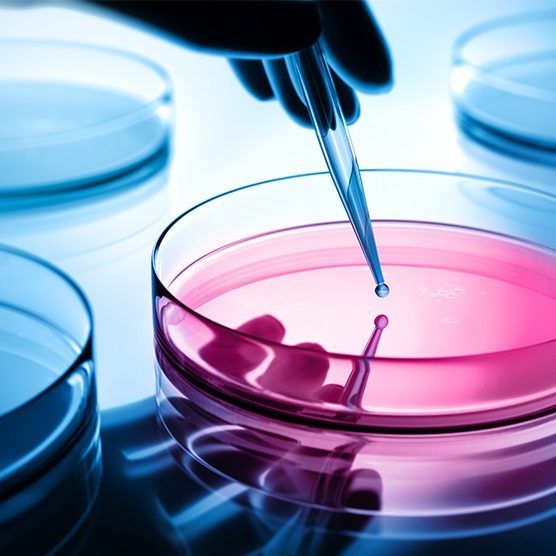

Client: Seven Media Group
Category: Product Design
Date: June 2019
Sellus honcus ornare sapien, et laoreet nisi malesuada eu tempus dictum. Morbi eu rutrum risus, vel vulputate odio dictum purus vel condimentum.
Proin condimentum congue tellus, sit amet rutrum augue interdum quis. Ut sollicitudin ligula id dui elementum, non blandit odio rhoncus.
Ut elit tellus, luctus nec ullamcorper mattis, pulvinar dapibus leo.
Ut sit amet semper ligula - purus vel condimentum
Lorem ipsum
Donec purus vel facilisis mi a lacus
Sellus honcus ornare
Sellus honcus ornare sapien, et laoreet nisi malesuada eu tempus dictum. Morbi eu rutrum risus, vel vulputate odio dictum purus vel condimentum. Ut sollicitudin ligula purus vel condimentum – id dui elementum, non blandit odio rhoncus. Donec facilisis mi a lacus elementumrhoncus. Nullam placerat tristique purus vel condimentum porta.
Sellus honcus ornare sapien, et laoreet nisi malesuada eu tempus dictum. Morbi eu rutrum risus, vel vulputate odio dictum purus vel condimentum.